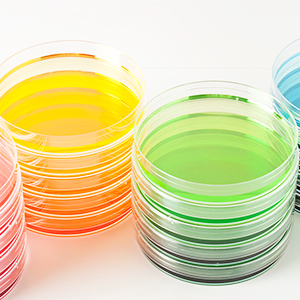

Kundendienst
Copyright © 2025 Desertcart Holdings Limited
Desert Online General Trading LLC
Dubai, United Arab Emirates






🔍 Unleash Your Inner Scientist!
This 30-pack of 90 x 15mm clear plastic petri dishes is perfect for educational projects, laboratory use, and creative party themes. Made from eco-friendly materials, these versatile dishes come with secure lids, making them ideal for everything from science experiments to unique gift packaging.

| Manufacturer | Hamiggaa |
| Part number | kaawdqel |
| Item Weight | 440 g |
| Package Dimensions | 37.6 x 26.7 x 11.2 cm; 440 g |
| Item model number | kaawdqel |
| Material | PLA_(Polylactic_Acid), PE_(Polyethylene), Plastic |
| Batteries included? | No |
| Batteries Required? | No |
TrustPilot
vor 2 Wochen
vor 2 Monaten